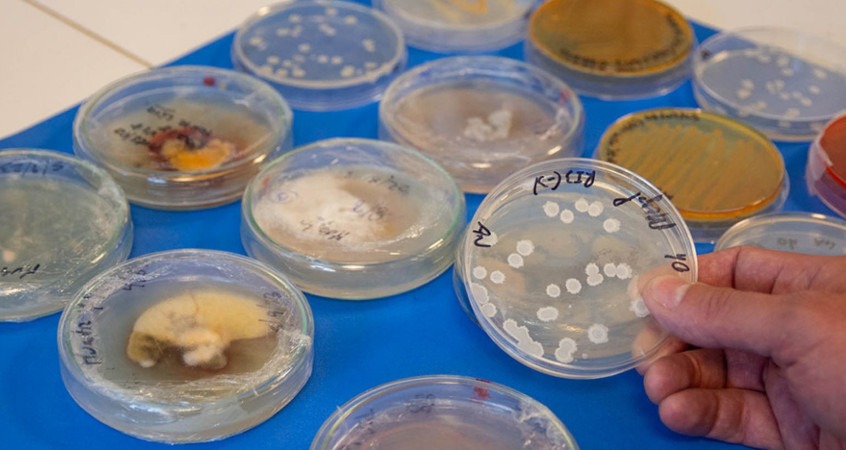
bioinsumos

El CeTBIO de Ciencias Agropecuarias transfiere conocimiento y tecnología en materia de bioinsumos, a través de convenios con empresas que, a su vez, permiten potenciar la investigación. Los proyectos que se vienen para reemplazar agroquímicos por productos naturales.
La solución al debate sobre el impacto ambiental que generan los agroquímicos podría estar en la misma naturaleza. Muchos microorganismos son eficientes como insecticidas, fertilizantes, fungicidas o herbicidas. Por lo tanto, si se los identifica con precisión, si se los caracteriza y se ponen a prueba pueden ser la materia prima para desarrollar productos biológicos para el sector agropecuario.
En eso trabaja el Centro de Transferencia de Bioinsumos (CeTBIO) de la Facultad de Ciencias Agropecuarias (FCA), que recientemente firmó su segundo contrato de transferencia con la empresa cordobesa Facyt, que se dedica a la comercialización de bioinsumos.
En 2018 se transfirió la tecnología de producción más la cepa de un hongo del género Trichoderma con capacidad fungicida y fertilizante. El nuevo convenio es para el asesoramiento científico-técnico en la elaboración de inoculantes a partir de bacterias del género Bacilllus.
Estos microorganismos, llamados promotores del crecimiento, potencian el crecimiento de las plantas y hacen más eficiente la forma en que estas usan los recursos del suelo y del agua. Además, también protegen a las plantas de organismos dañinos y las ayudan a sobreponerse ante situaciones ambientales desfavorables.
Hace 10 años que Facyt trabaja junto a investigadores e investigadoras de la FCA para potenciar las capacidades de la articulación público-privada.
“Todo arranca en la ciencia básica -cuenta Alejandro Pérez, director del CeTBIO-, con investigaciones. Luego hacemos prospección de suelos. Estudiamos la biología de la tierra y ponemos atención a lo que dice la bibliografía sobre el tema”.
“Hacemos cultivos en los laboratorios y obtenemos colonias de hongos y bacterias. Sacamos luego una célula o individuo de estas colonias y aislamos a nuestros microorganismos, para luego estudiarlos”, continúa.
Con el paso de los años, en Ciencias Agropecuarias de la UNC crearon un banco de cepas de hongos y bacterias de interés agropecuario. Antes de elegir el organismo indicado, se realizan múltiples pruebas. “Hay que medir la estabilidad de la cepa de acuerdo al tipo de ambiente en el que se va a utilizar”, aclara Pérez.
Hongos y bacterias multifunción
El organismo que más estudió y utilizó el equipo para el desarrollo de bioinsumos es el hongo llamado Trichoderma. “Es muy útil para el control de enfermedades y para mejorar la fertilidad de las plantas a partir de la siembra; logra que no sean atacados por patógenos. A su vez, le permite a la planta solubilizar nutrientes”, explica el ingeniero.
También trabajan con cepas de hongos como Beauveria, Metarhizium, Purpureocillium, que son para controlar insectos. Otra línea son las bacterias, que se complementan con los hongos para, por ejemplo, el control de enfermedades y de insectos, y para mejorar la calidad de los parámetros fisiológicos de las plantas.
“Tenemos un abanico de especies en nuestro banco para el desarrollo de insumos biológicos. La línea de investigación que impulsó CeTBIO en 2008 fue Trichoderma, que nos permitió elaborar insumos y transferirlos a dos grandes empresas de Córdoba”.
Otra de las ventajas de los insumos biológicos es que se pueden aplicar a distintos tipos de cultivos. “La selección de microorganismos que hacemos para una plaga específica se aplica en todo tipo de cultivo. Cuando se detecta que es estable, se usa por lo general con cierta transversalidad en los cultivos”, amplía Pérez.
¿Bioinsumos por agroquímicos?
“Los bioinsumos son alternativos y complementarios a los agroquímicos, dependiendo del tipo de cultivo”, opina el docente de la UNC. “Recomendamos aplicar bioinsumos donde el químico no lo afecte, pero también los vamos reemplazando. La idea es que estos productos naturales –que hoy se usan en no más del 10% de los campos de la Argentina- reemplacen en gran parte a los agroquímicos.
“Se puede hacer”, insiste Pérez. En muchos sistemas productivos hemos eliminado los productos químicos que se utilizan para el control de plagas y los reemplazamos por biológicos”.
El investigador de la UNC señala sobre este punto que es clave el rol de las universidades y del sector científico-tecnológico estatal para que traslade conocimiento a las empresas sobre las bondades y ventajas de los bioinsumos.
Directo a las empresas
El vínculo entre el Centro de Transferencia de Bioinsumos de la Facultad de Ciencias Agropecuarias y la empresa Facyt es el más productivo hasta ahora para el equipo de investigación y docencia de la UNC.
Hace algunos años recibieron 250 mil dólares de parte de la compañía para el desarrollo de los productos a base del hongo Trichoderma. Este fondo fue destinado a instalaciones, equipamiento, salarios y becas para investigación. Ahora se espera otra suma similar para invertir en el estudio de bacterias, cuyo proyecto lidera Ezequiel Bigatton -ingeniero agrónomo- junto al equipo de la cátedra de Microbiología Agrícola de la Facultad de Ciencias Agropecuarias de la UNC.
“Nuestro servicio va desde el desarrollo de la cepa hasta la producción, la capacitación al personal -para la venta- y a quien produce y compra el bioinsumo. Ofrecemos el know how completo. A Facyt le vendimos un servicio llave en mano”, cuenta Alejandro Pérez.
El bioinsumo a base de Trichoderma tiene funciones fungicidas y fertilizantes. Esta cepa se complementará con otro producto a base de bacterias del género Bacilllus, que en los próximos años permitirá finalizar los ensayos y contar con un producto biológico que incremente la tolerancia al estrés de las plantas para que puedan sortear mejor las sequías.
En el CeTBIO también existe un vínculo fuerte con la empresa SumaBio, ubicada en el interior de Córdoba, que se dedica exclusivamente a la comercialización de bioinsumos.
Además, el centro de transferencia de la UNC brinda servicios de asesoramiento y certificación a otras compañías.
“Trabajamos para unas 12 empresas que forman parte de la Cámara Argentina de Bioinsumos. Apoyamos su producción a través de la capacitación y la formación de recursos humanos”, cuenta Pérez.
Recientemente, Alejandro Pérez y otro miembro del CeTBIO crearon una empresa de base tecnológica dedicada a la formulación de bioinsumos llamada Microbial. La FCA-UNC fue beneficiada por esta creación ya que se pretende firmar convenios de cooperación para que se potencien ambas partes en aspectos tanto académicos como económicos. “Queremos crear una empresa híbrida. Mostrar que la vinculación pública y privada se puede concretar, que es un modelo a seguir en la Argentina”, asegura Pérez.
Por otro lado, Ezequiel Bigatton e Ibrahim Ayoub, otros miembros de CeTBIO, también participan de la creación de una empresa de base científico-tecnológica llamada Microvex, apoyada por el grupo inversor SF500 y por la aceleradora de la UNC que depende de la Secretaría de Innovación y Vinculación Tecnológica.
Por Lucas Gianre
FUENTE: Unciencia